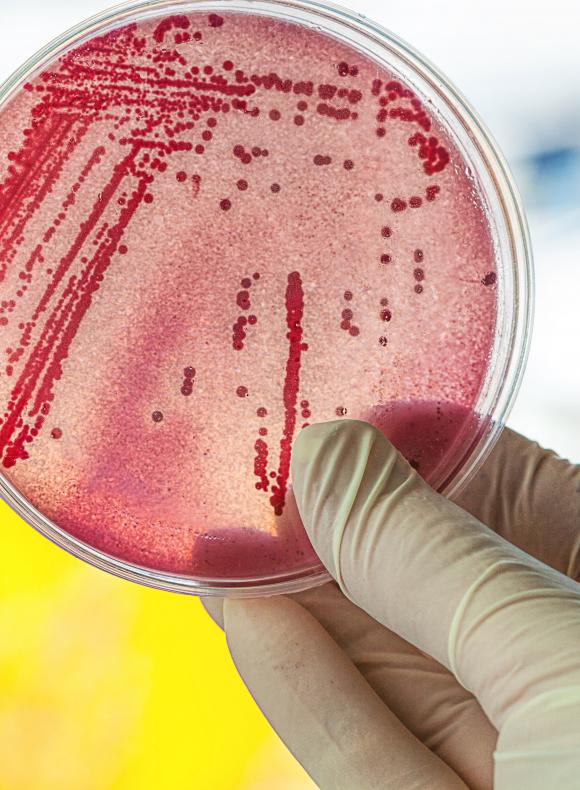
analisis de probeta en laboratorio

Diploma Universitario enBiotecnología
Modalidad
Presencial
Online
Nº de créditos
Desde 2 hasta 8 ECTS
TASA ACADÉMICA
Desde 580€
Duración
Desde 1 a 4 semanas
Campus
Murcia
¿Qué incluye la matrícula?
Matricula Presencial:
- Horas del profesorado UCAM
- Tickets de comida de Menú completo de nuestra cafetería (Durante los días de clases)
- Farewell Lunch
- Bono transporte público (a partir de 2 semanas)
- Welcome pack
- Material didáctico
- Certificado
- 1 Profesor / coordinador acompañante
¿Qué incluye la matricula Online?
- Horas del profesorado UCAM en campus virtual
- Material didáctico
- Certificado
Objetivos
- Obtener conocimientos en el área de biotecnológica que implican conocimientos procedentes de la vanguardia del área.
- Aplicar sus conocimientos a su trabajo de una forma profesional y tener las competencias que suelen demostrarse por medio de la elaboración y defensa de argumentos y la resolución de problemas dentro de su área de estudio.
- Ser capaz de reunir e interpretar datos relevantes para emitir juicios que incluyan una reflexión sobre temas relevantes de índole social, científica o ética.
- Transmitir información, ideas, problemas y soluciones a un público tanto especializado como no especializado.
- Tener habilidades de aprendizaje necesarias para emprender estudios posteriores con un alto grado de autonomía.